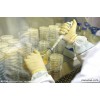

防尘等级 号码防护程度定义
0无防护无特殊的防护
1防止大于50mm之物体侵入,防止人体因不慎碰到灯具内部零件
2防止大于12mm之物体侵入,防止手指碰到灯具内部零件
3防止大于2.5mm之物全侵入,防止直径大于2.5mm的工具,电线或物体侵入
4防止大于1.0mm之物体侵入,防止直径大于1.0的蚊蝇、昆虫或物体侵入
5防尘无法完全防止灰尘侵入,但侵入灰尘量不会影响灯具正常运作
6防尘完全防止灰尘侵入
防水等级 号码防护程度定义
0无防护无特殊的防护
1防止滴水侵入防止垂直滴下之水滴
2倾斜15度时仍防止滴水侵入当灯具倾斜15度时,仍可防止滴水
3防止喷射的水侵入防止雨水、或垂直入夹角小于50度方向所喷射之水
4防止飞溅的水侵入防止各方向飞溅而来的水侵入
5防止大浪的水侵入防止大浪或喷水孔急速喷出的水侵入
6防止大浪的水侵入灯具侵入水中在一定时间或水压的条件下,仍可确保灯具正常运作
7防止侵水的水侵入灯具无期限的沉没水中在一定水压的条件下,及可确保灯具正常运作
8防止沉没的影响IP(INTERNATIONAL PROTECTION)等级所依据的标准有:1)由IEC(INTERNATIONAL ELECTROTECHNICAL COMMISSION)所起草国际防护和防水试验标准:国际电工委员会标准IEC 529–5982)国标GB 700–863)GB 4208等。
IP等级实验室:目前能进行IP等级试验的实验室主要有环境可靠性与电磁兼容试验中心,航天环境可靠性试验与检测中心等。